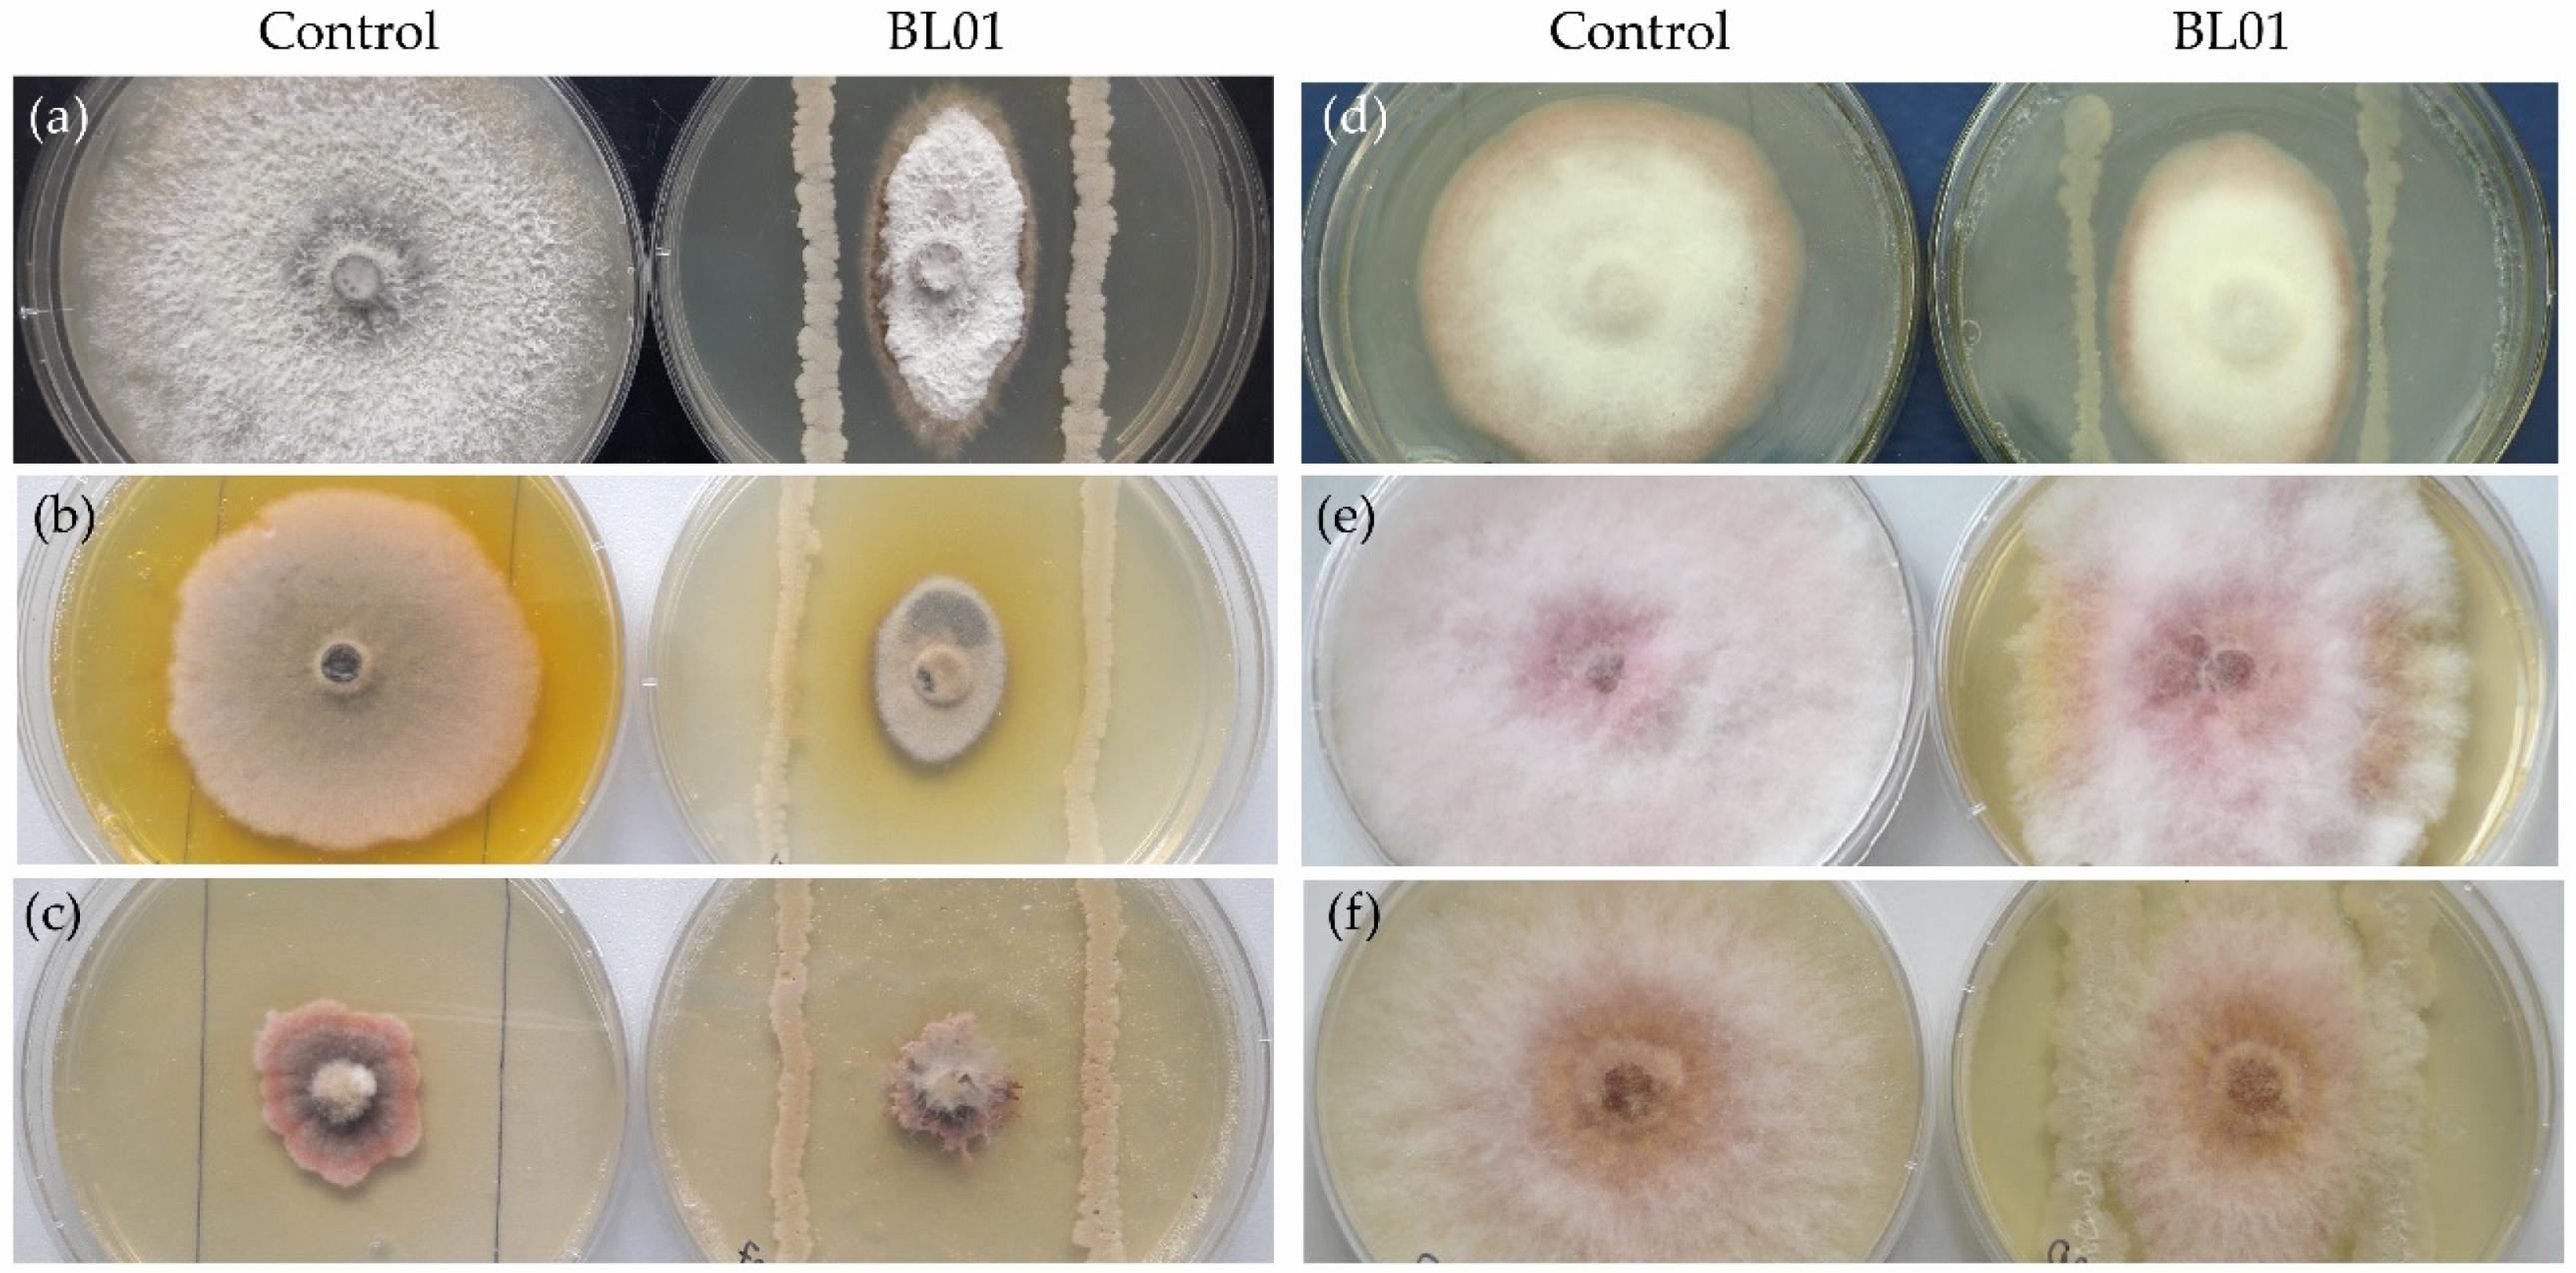
Horticulturae 10 01095 g003
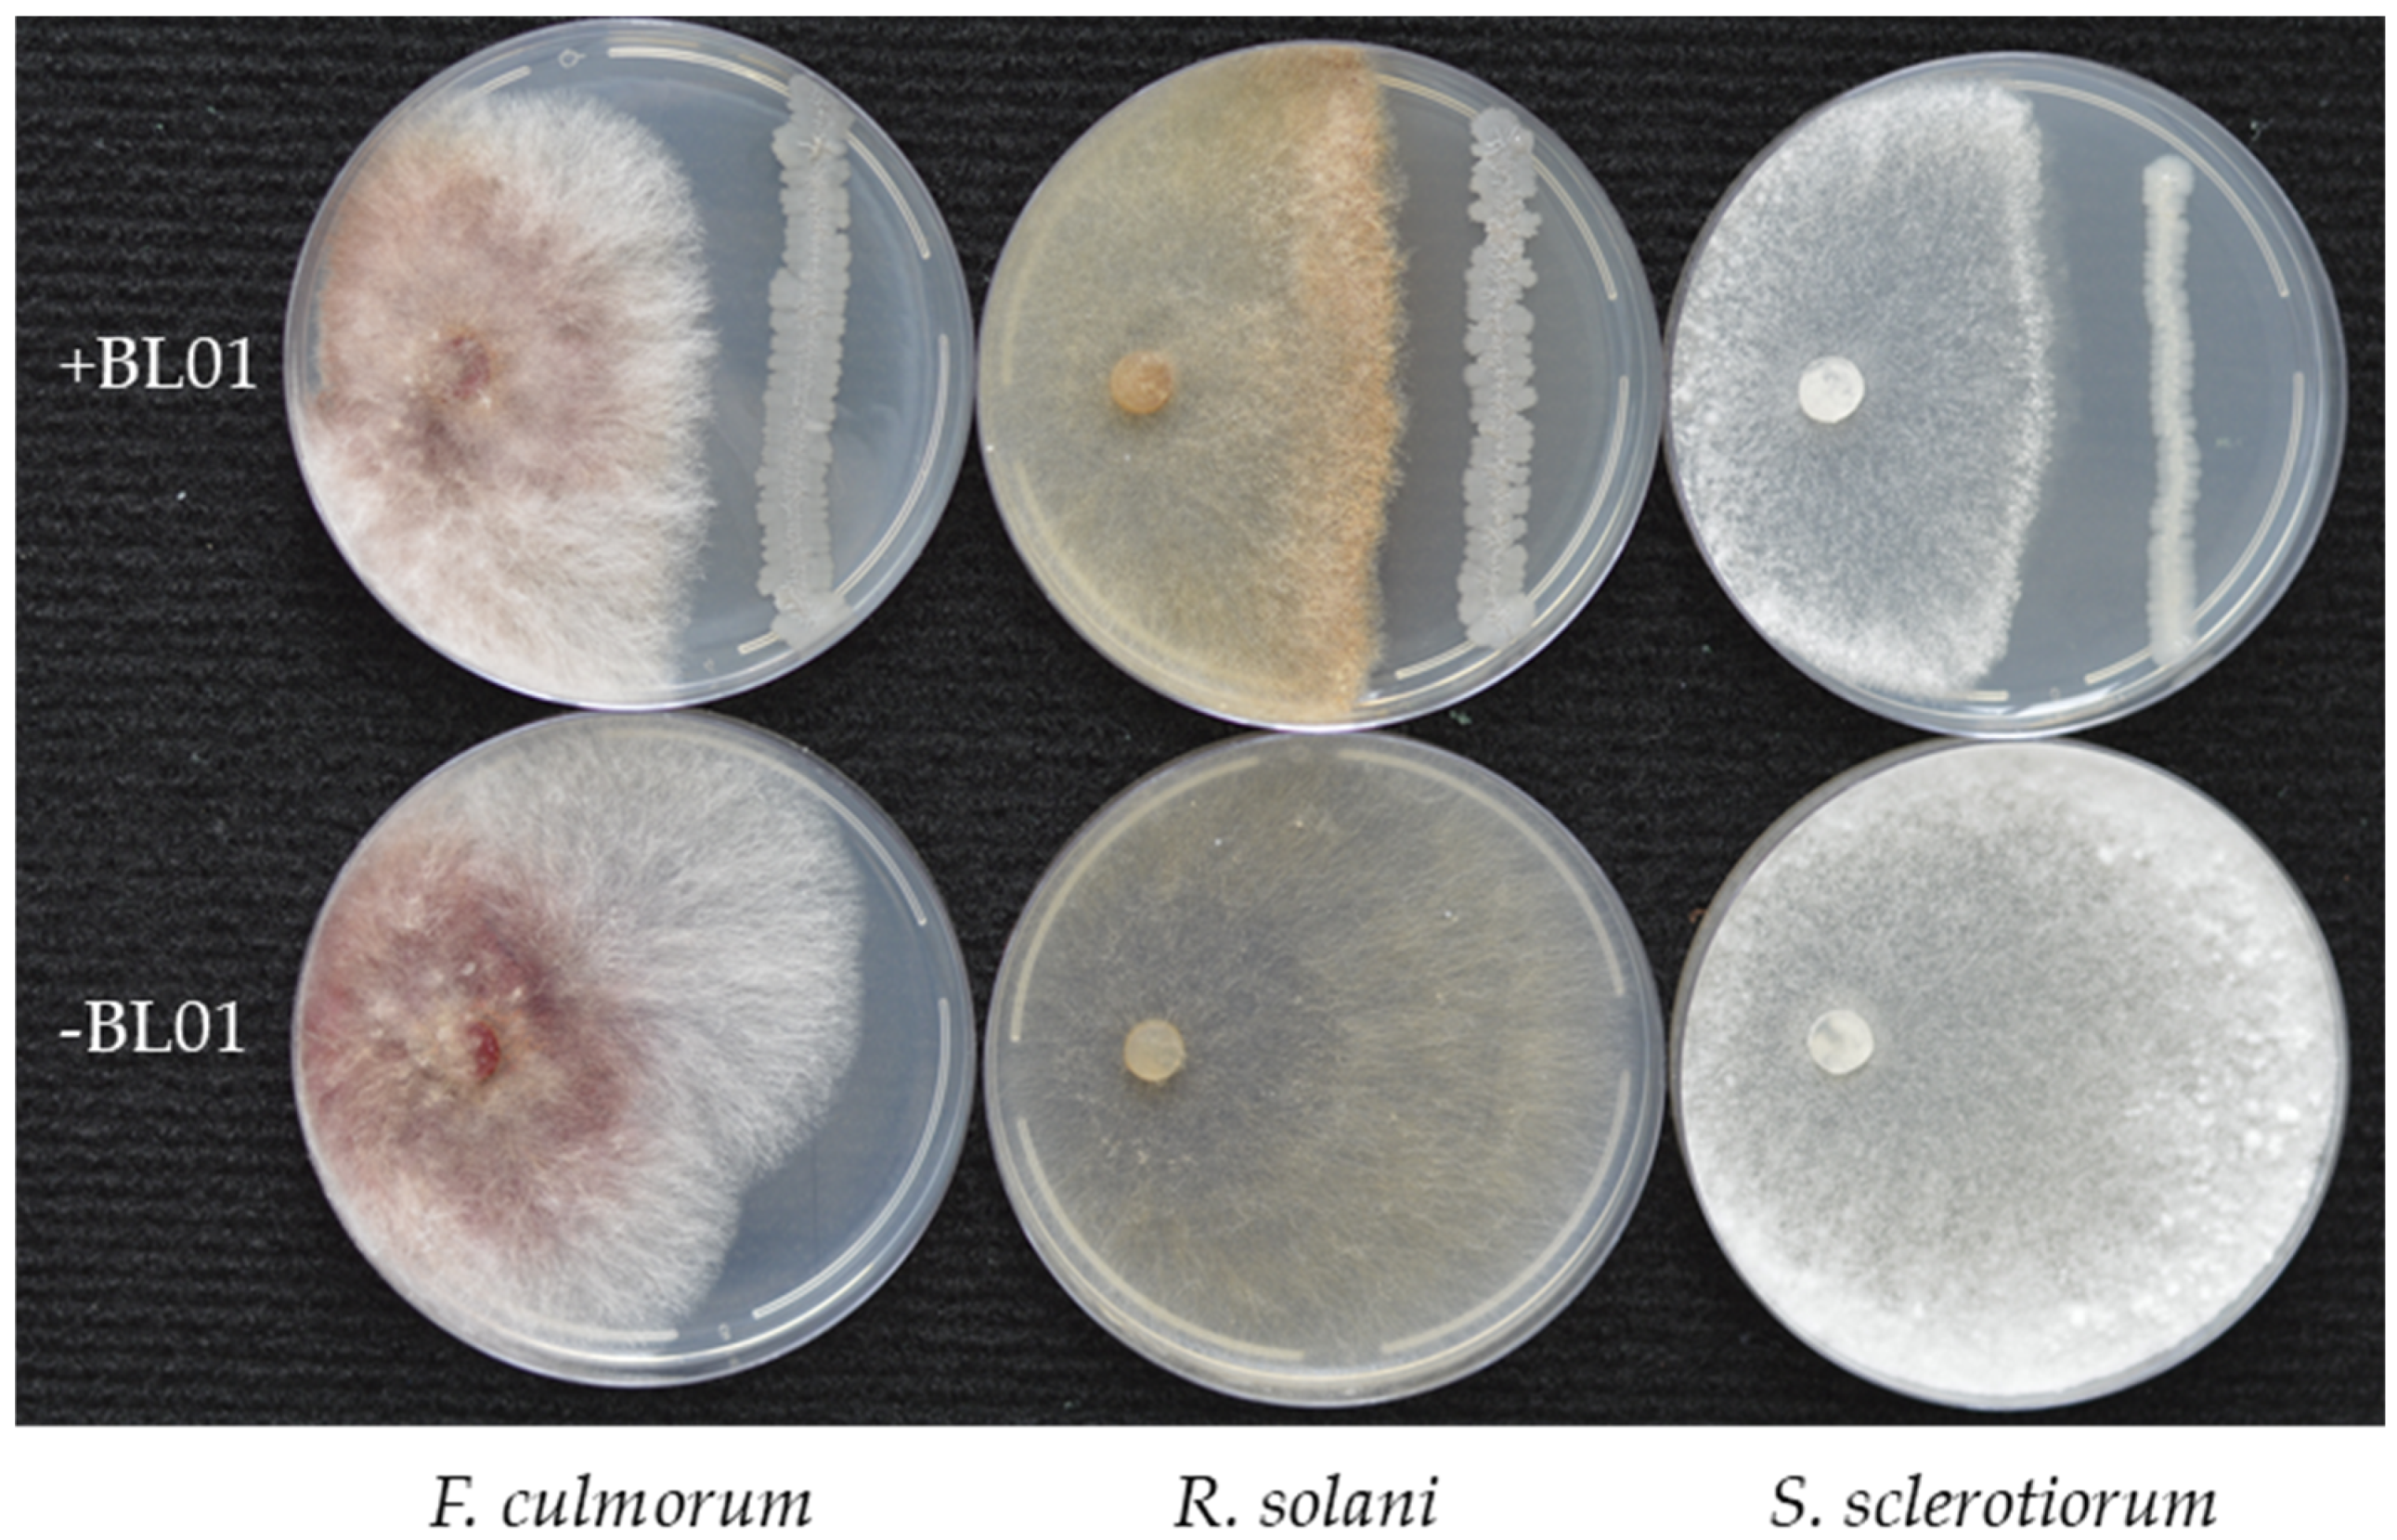
Horticulturae 10 01095 g005

Endophyte Bacillus vallismortis BL01 to Control Fungal and Bacterial Phytopathogens of Tomato (Solanum lycopersicum L.) Plants
Abstract
:1. Introduction
2. Materials and Methods
2.1. Determination of the Colonization Ability of B. vallismortis BL01
2.2. Root Colonization Study by Using Fluorescence In Situ Hybridization and Confocal Laser Scanning Microscopy
2.3. Evaluation of the Inhibitory Effect of B. vallismortis BL01 on the Phytopathogenic Fungi
2.4. Evaluation of the Inhibitory Effect of B. vallismortis BL01 on Phytopathogenic Bacteria
2.5. Field Tests with Tomato Plants under Natural Infection with Pathogens
- Control (background without treatments)
- B. vallismortis BL01-2 mL/kg of seeds (soaking) + 0.1% concentration (watering seedlings) + 3.0 L/ha (spraying three times)
- Biological standard Phytolavin—a streptotricin antibiotic complex (BA-120,000 EA/mL, 32 g/L), water-soluble concentrate, 2.0 L/ha (watering seedlings) + 2.0 L/ha (spraying three times)
2.6. Genome Analysis of B. vallismortis BL01
2.7. Statistical Analysis
3. Results
3.1. Colonization Ability of B. vallismortis BL01
3.2. Antifungal Activity of B. vallismortis BL01
3.3. Antibacterial Activity of B. vallismortis BL01
3.4. Field Tests with Tomato Plants and B. vallismortis BL01
3.5. Genome Features and Phylogeny of B. vallismortis BL01
3.6. Secondary Metabolic Potential of Strain BL01
4. Discussion
5. Conclusions
Supplementary Materials
Author Contributions
Funding
Data Availability Statement
Acknowledgments
Conflicts of Interest
References
- Tripathi, S.; Srivastava, P.; Devi, R.S.; Bhadouria, R. Influence of synthetic fertilizers and pesticides on soil health and soil microbiology. In Agrochemicals Detection, Treatment and Remediation; Butterworth-Heinemann: Oxford, UK, 2020; pp. 25–54. [Google Scholar]
- He, D.-C.; He, M.-H.; Amalin, D.M.; Liu, W.; Alvindia, D.G.; Zhan, J. Biological control of plant diseases: An evolutionary and eco-economic consideration. Pathogens 2021, 10, 1311. [Google Scholar] [CrossRef] [PubMed]
- FAOSTAT Database. Food and Agriculture Organization Statistics. Available online: https://www.fao.org/faostat/en/ (accessed on 23 August 2024).
- Ali, M.-Y.; Sina, A.A.I.; Khandker, S.S.; Neesa, L.; Tanvir, E.M.; Kabir, A.; Khalili, M.I.; Gan, S.H. Nutritional composition and bioactive compounds in tomatoes and their impact on human health and disease: A review. Foods 2018, 10, 45. [Google Scholar] [CrossRef] [PubMed]
- Montenegro, I.; Madrid, A.; Cuellar, M.; Seeger, M.; Alfaro, J.F.; Besoain, X.; Martínez, J.P.; Ramirez, I.; Olguín, Y.; Valenzuela, M. Biopesticide activity from drimanic compounds to control tomato pathogens. Molecules 2018, 23, 2053. [Google Scholar] [CrossRef]
- Panno, S.; Davino, S.; Caruso, A.G.; Bertacca, S.; Crnogorac, A.; Mandić, A.; Noris, E.; Matić, S. A review of the most common and economically important diseases that undermine the cultivation of tomato crop in the Mediterranean Basin. Agronomy 2021, 11, 2188. [Google Scholar] [CrossRef]
- Attia, M.S.; El-Wakil, D.A.; Hashem, A.H.; Abdelaziz, A. Antagonistic effect of plant growth-promoting fungi against fusarium wilt disease in tomato: In vitro and in vivo study. Appl. Biochem. Biotechnol. 2022, 194, 5100–5118. [Google Scholar] [CrossRef]
- Tudi, M.; Ruan, H.D.; Wang, L.; Lyu, J.; Sadler, R.; Connell, D.; Chu, C.; Phung, D.T. Agriculture development, pesticide application and its impact on the environment. Int. J. Environ. Res. Public Health 2021, 18, 1112. [Google Scholar] [CrossRef] [PubMed]
- Kumari, M.; Qureshi, K.A.; Jaremko, M.; White, J.F.; Singh, S.K.; Sharma, V.K.; Singh, K.K.; Santoyo, G.; Puopolo, G.; Kumar, A. Deciphering the role of endophytic microbiome in postharvest diseases management of fruits: Opportunity areas in commercial up-scale production. Front. Plant Sci. 2022, 13, 1026575. [Google Scholar] [CrossRef]
- Lahlali, R.; Ezrari, S.; Radouane, N.; Kenfaoui, J.; Esmaeel, Q.; El Hamss, H.; Belabess, Z.; Barka, E.A. Biological Control of Plant Pathogens: A Global Perspective. Microorganisms 2022, 10, 596. [Google Scholar] [CrossRef]
- Karačić, V.; Miljaković, D.; Marinković, J.; Ignjatov, M.; Milošević, D.; Tamindžić, G.; Ivanović, M. Bacillus species: Excellent biocontrol agents against tomato diseases. Microorganisms 2024, 12, 457. [Google Scholar] [CrossRef]
- Schulz, B.J.; Boyle, C. What are endophytes? In Microbial Root Endophytes; Schulz, B.J.E., Boyle, C.J.C., Sieber, T.N., Eds.; Springer: Berlin, Germany, 2006; pp. 1–13. [Google Scholar]
- Hardoim, P.R.; van Overbeek, L.S.; van Elsas, J.D. Properties of bacterial endophytes and their proposed role in plant growth. Trends Microbiol. 2008, 16, 463–471. [Google Scholar] [CrossRef]
- Redecker, D.; Kodner, R.; Graham, L.E. Glomalean fungi from the Ordovician. Science 2000, 289, 1920–1921. [Google Scholar] [CrossRef] [PubMed]
- Krings, M.; Taylor, T.N.; Hass, H.; Kerp, H.; Dotzler, N.; Hermsen, E.J. Fungal endophytes in a 400-millionyr-old land plant: Infection pathways, spatial distribution, and host responses. New Phytol. 2007, 174, 648–657. [Google Scholar] [CrossRef] [PubMed]
- Chebotar, V.; Malfanova, N.; Shcherbakov, A.; Ahtemova, G.; Borisov, A.Y.; Lugtenberg, B.; Tikhonovich, I. Endophytic bacteria in microbial drugs that improve plant development. Appl. Biochem. Microbiol. 2015, 51, 271–277. [Google Scholar] [CrossRef]
- Tontou, R.; Gaggia, F.; Baffoni, L.; Devescovi, G.; Venturi, V.; Giovanardi, D.; Stefani, E. Molecular characterization of an endophyte showing a strong antagonistic activity against Pseudomonas syringae pv. actinidiae. Plant Soil. 2015, 405, 97–106. [Google Scholar] [CrossRef]
- Morales-Cedeño, L.R.; Orozco-Mosqueda, M.C.; Loeza-Lara, P.D.; Parra-Cota, F.I.; de los Santos-Villalobos, S.; Santoyo, G. Plant growth-promoting bacterial endophytes as biocontrol agents of pre- and post-harvest diseases: Fundamentals, methods of application and future perspectives. Microbiol. Res. 2021, 242, 126612. [Google Scholar] [CrossRef]
- Kashyap, N.; Singh, S.K.; Yadav, N.; Singh, V.K.; Kumari, M.; Kumar, D.; Shukla, L.; Kaushalendra; Bhardwaj, N.; Kumar, A. Biocontrol Screening of Endophytes: Applications and Limitations. Plants 2023, 12, 2480. [Google Scholar] [CrossRef]
- Ryan, R.P.; Germaine, K.; Franks, A.; Ryan, D.J.; Dowling, D.N. Bacterial endophytes: Recent developments and applications. FEMS Microbiol. Lett. 2008, 278, 1–9. [Google Scholar] [CrossRef] [PubMed]
- Wang, Y.; Zhang, Y.; Gao, Z.; Yang, W. Breeding for resistance to tomato bacterial diseases in China: Challenges and prospects. Hortic. Plant J. 2018, 4, 193–207. [Google Scholar] [CrossRef]
- Peňázová, E.; Dvořák, M.; Ragasová, L.; Kiss, T.; Pečenka, J.; Čechová, J.; Eichmeier, A. Multiplex real-time PCR for the detection of Clavibacter michiganensis subsp. michiganensis, Pseudomonas syringae pv. tomato and pathogenic Xanthomonas species on tomato plants. PLoS ONE 2020, 15, e0227559. [Google Scholar] [CrossRef]
- Jacobsen, B.J.; Zidack, N.K.; Larson, B.J. The role of Bacillus-based biological control agents in integrated pest management systems: Plant diseases. Phytopathology 2004, 94, 1272–1275. [Google Scholar] [CrossRef]
- Latha, P.; Karthikeyan, M.; Rajeswari, E. Endophytic bacteria: Prospects and applications for the plant disease management. In Plant Health under Biotic Stress; Ansari, R., Mahmood, I., Eds.; Springer: Singapore, 2019; pp. 1–50. [Google Scholar] [CrossRef]
- Chebotar, V.K.; Zaplatkin, A.N.; Komarova, O.V.; Baganova, M.E.; Chizhevskaya, E.P.; Polukhin, N.I.; Balakina, S.V. Endophytic bacteria for development of microbiological preparations for increasing productivity and protection of new potato varieties. Res. Crops 2021, 22, 104–107. [Google Scholar] [CrossRef]
- Chebotar, V.K.; Zaplatkin, A.N.; Balakina, S.V.; Gadzhiev, N.M.; Lebedeva, V.A.; Khiutti, A.V.; Chizhevskaya, E.P.; Filippova, P.S.; Keleinikova, O.V.; Baganova, M.E.; et al. The effect of endophytic bacteria Bacillus thuringiensis W65 and B. amyloliquefaciens P20 on the yield and the incidence of potato rhizoctoniosis and late blight. Sel’skokhozyaistvennaya Biol. 2023, 58, 429–446. [Google Scholar] [CrossRef]
- Cook, R.J. Making greater use of introduced microorganisms for biological control of plant pathogens. Annu. Rev. Phytopathol. 1993, 31, 53–80. [Google Scholar] [CrossRef] [PubMed]
- Brimner, T.A.; Boland, G.J. A review of the non-target effects of fungi used to biologically control plant diseases. Agric. Ecosyst. Environ. 2003, 100, 3–16. [Google Scholar] [CrossRef]
- Pal, K.K.; Gardener, B.M. Biological control of plant pathogens. Plant Health Instr. 2006, 2, 1117–1142. [Google Scholar] [CrossRef]
- Zhao, Z.; Wang, Q.; Wang, K.; Brian, K.; Liu, C.; Gu, Y. Study of the antifungal activity of Bacillus vallismortis ZZ185 in vitro and identification of its antifungal components. Bioresour. Technol. 2010, 101, 292–297. [Google Scholar] [CrossRef]
- Castaldi, S.; Petrillo, C.; Donadio, G.; Piaz, F.D.; Cimmino, A.; Masi, M.; Evidente, A.; Isticato, R. Plant growth promotion function of Bacillus sp. strains isolated from salt-pan rhizosphere and their biocontrol potential against Macrophomina phaseolina. Int J. Mol Sci. 2021, 22, 3324. [Google Scholar] [CrossRef]
- Park, K.S.; Paul, D.; Ryu, K.R.; Kim, E.Y.; Kim, Y.K. Bacillus vallismortis strain EXTN-1 mediated systemic resistance against potato virus Y and X in the field. Plant Pathol. J. 2006, 22, 360–363. [Google Scholar] [CrossRef]
- Park, K.S.; Diby, P.; Kim, Y.K.; Nam, K.W.; Lee, Y.K.; Choi, H.W.; Lee, S.Y. Induced systemic resistance by Bacillus vallismortis EXTN-1 suppressed bacterial wilt in tomato caused by Ralstonia solanacearum. Plant Pathol. J. 2007, 23, 22–25. [Google Scholar] [CrossRef]
- Park, J.-W.; Balaraju, K.; Kim, J.-W.; Lee, S.-W.; Park, K. Systemic resistance and growth promotion of chili pepper induced by an antibiotic producing Bacillus vallismortis strain BS07. Biol. Control 2013, 65, 246–257. [Google Scholar] [CrossRef]
- Park, K.; Park, Y.S.; Ahamed, J.; Dutta, S.; Ryu, H.; Lee, S.H.; Balaraju, K.; Manir, M.; Moon, S.S. Elicitation of induced systemic resistance of chili pepper by iturin A analogs derived from Bacillus vallismortis EXTN-1. Can. J. Plant Sci. 2016, 96, 564–570. [Google Scholar] [CrossRef]
- Wilson, M.; Campbell, H.L.; Ji, P.; Jones, J.B.; Cuppels, D.A. Biological control of bacterial speck of tomato under Weld conditions at several locations in North America. Phytopathology 2002, 92, 1284–1292. [Google Scholar] [CrossRef] [PubMed]
- Byrne, J.M.; Dianese, A.C.; Ji, P.; Campbell, H.L.; Cuppels, D.A.; Louws, F.J.; Miller, S.A.; Jones, J.B.; Wilson, M. Biological control of bacterial spot of tomato under field conditions at several locations in North America. Biol. Control 2005, 32, 408–418. [Google Scholar] [CrossRef]
- Chebotar, V.K.; Gancheva, M.S.; Chizhevskaya, E.P.; Keleinikova, O.V.; Baganova, M.E.; Zaplatkin, A.N.; Pishchik, V.N. Draft genome sequence of Bacillus vallismortis strain BL01, isolated from Artemisia lerchiana Web. Roots. Microbiol. Resour. Announc. 2022, 11, e00647-22. [Google Scholar] [CrossRef]
- Chebotar, V.K.; Makarova, N.M.; Shaposhnikov, A.I.; Kravchenko, L.V. Antifungal and phytostimulating characteristics of Bacillus subtilis Ch-13 rhizospheric strain, producer of bioprepations. Appl. Biochem. Microbiol. 2009, 45, 419–423. [Google Scholar] [CrossRef]
- Simons, M.; Bij, A.J.; Brand, I.; De Weger, L.; Wijffelman, C.A.; Lugtenberg, B. Gnotobiotic system for studying rhizosphere colonization by plant growth-promoting Pseudomonas bacteria. Mol. Plant Microbe Interact. 1996, 9, 600–607. [Google Scholar] [CrossRef]
- Müller, H.; Berg, G. Impact of formulation procedures on the effect of the biocontrol agent Serratia plymuthica HRO-C48 on Verticillium wilt in oilseed rape. BioControl 2008, 53, 905–913. [Google Scholar] [CrossRef]
- Cardinale, M.; de Castro, J.V.; Müller, H.; Berg, G.; Grube, M. In situ analysis of the bacterial community associated with the reindeer lichen Cladonia arbuscula reveals predominance of Alphaproteobacteria. FEMS Microbiol. Ecol. 2008, 66, 63–71. [Google Scholar] [CrossRef] [PubMed]
- Zhang, C.; Cai, K.; Li, M.; Zheng, J.; Han, Y. Plant-growth-promoting potential of PGPE isolated from Dactylis glomerata L. Microorganisms 2022, 10, 731. [Google Scholar] [CrossRef]
- Zenova, G.M.; Stepanov, A.L.; Likhachev, A.A.; Manucharova, N.A. Praktikum po Biologii Pochv (Manual on Soil Biology); Moscow State University Publishing House: Moscow, Russia, 2002; 120p. (In Russian) [Google Scholar]
- Dolzhenko, V.I. Guidelines for Registration Tests of Fungicides in Agriculture; VIZR: Saint-Petersburg, Russia, 2009; 37p. (In Russian) [Google Scholar]
- Tatusova, T.; DiCuccio, M.; Badretdin, A.; Chetvernin, V.; Nawrocki, E.P.; Zaslavsky, L.; Lomsadze, A.; Pruitt, K.D.; Borodovsky, M.; Ostell, J. NCBI prokaryotic genome annotation pipeline. Nucleic Acids Res. 2016, 44, 6614–6624. [Google Scholar] [CrossRef]
- Grant, J.R.; Enns, E.; Marinier, E.; Mandal, A.; Herman, E.K.; Chen, C.Y.; Graham, M.; Van Domselaar, G.; Stothard, P. Proksee: In-depth characterization and visualization of bacterial genomes. Nucleic Acids Res. 2023, 51, 484–492. [Google Scholar] [CrossRef] [PubMed]
- Blin, K.; Shaw, S.; Kloosterman, A.M.; Charlop-Powers, Z.; van Wezel, G.P.; Medema, M.H.; Weber, T. antiSMASH 6.0: Improving cluster detection and comparison capabilities. Nucleic Acids Res. 2021, 49, 29–35. [Google Scholar] [CrossRef] [PubMed]
- Xu, L.; Dong, Z.; Fang, L.; Luo, Y.; Wei, Z.; Guo, H.; Zhang, G.; Gu, Y.Q.; Coleman-Derr, D.; Xia, Q.; et al. OrthoVenn2: A web server for whole-genome comparison and annotation of orthologous clusters across multiple species. Nucleic Acids Res. 2019, 47, 52–58. [Google Scholar] [CrossRef]
- Borriss, R. Bacillus, a plant beneficial bacterium. In Principles of Plant-Microbe Interactions. Microbes for Sustainable Agriculture; Lugtenberg, B., Ed.; Springer: Berlin, Germany, 2015; pp. 379–391. [Google Scholar] [CrossRef]
- Serrão, C.P.; Ortega, J.C.G.; Rodrigues, P.C.; de Souza, C.R.B. Bacillus species as tools for biocontrol of plant diseases: A meta-analysis of twenty-two years of research, 2000-2021. World J. Microbiol. Biotechnol. 2024, 40, 110. [Google Scholar] [CrossRef]
- Roberts, M.S.; Nakamura, L.K.; Cohan, F.M. Bacillus vallismortis sp. nov., a close relative of Bacillus subtilis, isolated from soil in Death Valley, California. Int. J. Syst. Bacteriol. 1996, 46, 470–475. [Google Scholar] [CrossRef] [PubMed]
- Wang, Y.; Yang, C.; Yao, Y.; Wang, Y.; Zhang, Z.; Xue, L. The diversity and potential function of endophytic bacteria isolated from Kobreasia capillifolia at alpine grasslands on the Tibetan Plateau, China. J. Integr. Agric. 2016, 15, 2153–2162. [Google Scholar] [CrossRef]
- Munir, S.; Li, Y.; He, P.; Huang, M.; He, P.; He, P.; Cui, W.; Wu, Y.; He, Y. Core endophyte communities of different citrus varieties from citrus growing regions in China. Sci. Rep. 2020, 10, 3648. [Google Scholar] [CrossRef]
- Irabor, A.; Mmbaga, M.T. Evaluation of selected bacterial endophytes for biocontrol potential against phytophthora blight of bell pepper (Capsicum annuum L.). J. Plant Pathol. Microbiol. 2017, 8, 1000424. [Google Scholar] [CrossRef]
- Jamwal, V.L.; Gulfam, S.; Manhas, R.S.; Qayum, A.; Kapoor, N.; Chouhan, R.; Singh, S.K.; Chaubey, A.; Gandhi, S.G. Isolation, identification and bioactive potential of bacterial endophytes from Coleus. Indian J. Biochem. Biophys. 2019, 56, 392–398. [Google Scholar]
- Khan, T.; Abbasi, B.H.; Iqrar, I.; Khan, M.A.; Shinwari, Z.K. Molecular identification and control of endophytic contamination during in vitro plantlet development of Fagonia indica. Acta Physiol. Plant. 2018, 40, 150. [Google Scholar] [CrossRef]
- Kandel, S.; Joubert, P.; Doty, S. Bacterial endophyte colonization and distribution within plants. Microorganisms 2017, 5, 77. [Google Scholar] [CrossRef] [PubMed]
- Mercado-Blanco, J. Life of microbes inside the plant. In Principles of Plant-Microbe Interactions; Lugtenberg, B.J.J., Ed.; Springer International Publishing: Berlin, Germany, 2015; pp. 25–32. [Google Scholar]
- Volynchikova, E.; Kim, K.D. Anti-oomycete activity and pepper root colonization of Pseudomonas plecoglossicida YJR13 and Pseudomonas putida YJR92 against Phytophthora capsica. Plant Pathol J. 2023, 39, 123–135. [Google Scholar] [CrossRef] [PubMed]
- Algam, S.A.; Guan-lin, X.; Coosemans, J. Delivery methods for introducing endophytic Bacillus into tomato and their effect on growth promotion and suppression of tomato wilt. Plant Pathol J. 2005, 4, 69–74. [Google Scholar] [CrossRef]
- Joshua, J.; Mmbaga, M. Potential biological control agents for soilborne fungal pathogens in Tennessee snap bean farms. HortScience 2020, 55, 988–994. [Google Scholar] [CrossRef]
- Duan, Y.; Chen, R.; Zhang, R.; Jiang, W.; Chen, X.; Yin, C.; Mao, Z. Isolation and identification of Bacillus vallismortis HSB-2 and its biocontrol potential against apple replant disease. Biol. Control 2022, 170, 104921. [Google Scholar] [CrossRef]
- Kaur, P.K.; Kaur, J.; Saini, H.S. Antifungal potential of Bacillus vallismortis R2 against different phytopathogenic fungi. Span. J. Agric. Res. 2015, 13, e1004. [Google Scholar] [CrossRef]
- Zhao, P.; Xue, Y.; Gao, W.; Li, J.; Zu, X.; Fu, D. Bacillaceae—Derived peptide antibiotics since 2000. Peptides 2018, 101, 10–16. [Google Scholar] [CrossRef]
- Li, Y.; Wang, R.; Liu, J.; Xu, L.; Ji, P.; Sun, L.; Pan, H.; Jiang, B.; Li, L. Identification of a biocontrol agent Bacillus vallismortis BV23 and assessment of effects of its metabolites on Fusarium graminearum causing corn stalk rot. Biocontrol Sci. Technol. 2018, 29, 263–273. [Google Scholar] [CrossRef]
- Noh, S.W.; Seo, R.; Park, J.K.; Manir, M.M.; Park, K.; Sang, M.K.; Moon, S.S.; Jung, H.W. Cyclic dipeptides from Bacillus vallismortis BS07 require key components of plant immunity to induce disease resistance in Arabidopsis against Pseudomonas infection. Plant Pathol. J. 2017, 33, 402–409. [Google Scholar] [CrossRef]
- Zhang, H.; Yang, X.M.; Ran, W.; Xu, Y.C.; Shen, Q.R. Screening of bacterial antagonistic against soil-borne cotton Verticillium wilt and their biological effects on the soil cotton system. Acta Pedol. Sin. 2008, 45, 1095–1100. [Google Scholar]
- Ongena, M.; Jacques, P. Bacillus lipopeptides: Versatile weapons for plant disease biocontrol. Trends Microbiol. 2008, 16, 115–125. [Google Scholar] [CrossRef]
- Raaijmakers, J.M.; de Bruijn, I.; Nybroe, O.; Ongena, M. Natural functions of lipopeptides from Bacillus and Pseudomonas: More than surfactants and antibiotics. FEMS Microbiol. Rev. 2010, 34, 1037–1062. [Google Scholar] [CrossRef] [PubMed]
- Malfanova, N.; Franzil, L.; Lugtenberg, B.; Chebotar, V.; Ongena, M. Cyclic lipopeptide profile of the plant-beneficial endophytic bacterium Bacillus subtilis HC8. Arch. Microbiol. 2012, 194, 893–899. [Google Scholar] [CrossRef] [PubMed]
- Cochrane, S.A.; Vederas, J.C. Lipopeptides from Bacillus and Paenibacillus spp. a gold mine of antibiotic candidates. Med. Res. Rev. 2016, 36, 4–31. [Google Scholar] [CrossRef] [PubMed]
- Thasana, N.; Prapagdee, B.; Rangkadilok, N.; Sallabhan, R.; Aye, S.L.; Ruchirawat, S.; Loprasert, S. Bacillus subtilis SSE4 produces subtulene A, a new lipopeptide antibiotic possessing an unusual C15 unsaturated β-amino acid. FEBS Lett. 2010, 5844, 3209–3214. [Google Scholar] [CrossRef]
- Medeot, D.B.; Fernandez, M.; Morales, G.M.; Jofré, E. Fengycins from Bacillus amyloliquefaciens MEP218 exhibit antibacterial activity by producing alterations on the cell surface of the pathogens Xanthomonas axonopodis pv. vesicatoria and Pseudomonas aeruginosa PA01. Front. Microbiol. 2020, 10, 3107. [Google Scholar] [CrossRef]
- Grady, E.N.; MacDonald, J.; Ho, M.T.; Weselowski, B.; McDowell, T.; Solomon, O.; Renaud, J.; Yuan, Z.C. Characterization and complete genome analysis of the surfactin-producing, plant-protecting bacterium Bacillus velezensis 9D-6. BMC Microbiol. 2019, 19, 5. [Google Scholar] [CrossRef]
- Hamley, I.W. Lipopeptides: From self-assembly to bioactivity. Chem. Commun. 2015, 51, 74–83. [Google Scholar] [CrossRef]
- Thepbandit, W.; Srisuwan, A.; Siriwong, S.; Nawong, S.; Athinuwat, D. Bacillus vallismortis TU-Orga21 blocks rice blast through both direct effect and stimulation of plant defense. Front. Plant Sci. 2023, 14, 1103487. [Google Scholar] [CrossRef]

| Accession Number | CP092751 |
|---|---|
| Assembly method | SPAdes v. 3.14.1 |
| Genome coverage | 43.0× |
| Sequencing technology | Illumina HiSeq |
| Total sequence length | 4,115,091 |
| Annotation pipeline | NCBI Prokaryotic Genome Annotation Pipeline (PGAP) |
| Annotation method | Best-placed reference protein set; GeneMarkS-2+ |
| Annotation software revision | 6.1 |
| Genes (total) | 4123 |
| CDSs (total) | 4029 |
| Genes (coding) | 3900 |
| Pseudo genes | 129 |
| Genes (RNA) | 94 |
| rRNAs | 9 |
| tRNAs | 80 |
| ncRNAs | 5 |
| Region | Type | Genome Locations | Most Similar Known Cluster | Similarity with the antiSMASH Database | |
|---|---|---|---|---|---|
| 1 | Ranthipeptide- sactipeptide | 167692-189797 | sporulation killing factor | RiPP:Head-to-tail cyclized peptide | 100% |
| 2 | NRPS | 321941-386583 | surfactin | NRP:Lipopeptide | 82% |
| 3 | NRPS, T1PKS | 640163-720769 | zwittermicin A | NRP + polyketide | 18% |
| 4 | transAT-PKS | 1501848-1591234 | macrolactin H | Polyketide | 100% |
| 5 | transAT-PKS, PKS- like NRPS | 1816614-1921458 | bacillaene | Polyketide + NRP | 100% |
| 6 | NRPS, transAT- PKS, betalactone | 1982463-2109472 | fengycin | NRP | 100% |
| 7 | terpene | 2171729-2193627 | |||
| 8 | T3PKS | 2240506-2281603 | |||
| 9 | NRPS | 3123215-3170351 | bacillibactin | NRP | 100% |
| 10 | CDPS | 3460672-3481418 | |||
| 11 | sactipeptide | 3703716-3725326 | subtilosin A | RiPP:Thiopeptide | 100% |
| 12 | other | 3728594-3770012 | bacilysin | Other | 100% |
| 13 | epipeptide | 3982227-4003928 | thailanstatin A | NRP + polyketide | 10% |
Disclaimer/Publisher’s Note: The statements, opinions and data contained in all publications are solely those of the individual author(s) and contributor(s) and not of MDPI and/or the editor(s). MDPI and/or the editor(s) disclaim responsibility for any injury to people or property resulting from any ideas, methods, instructions or products referred to in the content. |
© 2024 by the authors. Licensee MDPI, Basel, Switzerland. This article is an open access article distributed under the terms and conditions of the Creative Commons Attribution (CC BY) license (https://creativecommons.org/licenses/by/4.0/).
Share and Cite
Chebotar, V.K.; Gancheva, M.S.; Chizhevskaya, E.P.; Erofeeva, A.V.; Khiutti, A.V.; Lazarev, A.M.; Zhang, X.; Xue, J.; Yang, C.; Tikhonovich, I.A. Endophyte Bacillus vallismortis BL01 to Control Fungal and Bacterial Phytopathogens of Tomato (Solanum lycopersicum L.) Plants. Horticulturae 2024, 10, 1095. https://doi.org/10.3390/horticulturae10101095
Chebotar VK, Gancheva MS, Chizhevskaya EP, Erofeeva AV, Khiutti AV, Lazarev AM, Zhang X, Xue J, Yang C, Tikhonovich IA. Endophyte Bacillus vallismortis BL01 to Control Fungal and Bacterial Phytopathogens of Tomato (Solanum lycopersicum L.) Plants. Horticulturae. 2024; 10(10):1095. https://doi.org/10.3390/horticulturae10101095
Chicago/Turabian StyleChebotar, Vladimir K., Maria S. Gancheva, Elena P. Chizhevskaya, Anastasia V. Erofeeva, Alexander V. Khiutti, Alexander M. Lazarev, Xiuhai Zhang, Jing Xue, Chunhong Yang, and Igor A. Tikhonovich. 2024. "Endophyte Bacillus vallismortis BL01 to Control Fungal and Bacterial Phytopathogens of Tomato (Solanum lycopersicum L.) Plants" Horticulturae 10, no. 10: 1095. https://doi.org/10.3390/horticulturae10101095
APA StyleChebotar, V. K., Gancheva, M. S., Chizhevskaya, E. P., Erofeeva, A. V., Khiutti, A. V., Lazarev, A. M., Zhang, X., Xue, J., Yang, C., & Tikhonovich, I. A. (2024). Endophyte Bacillus vallismortis BL01 to Control Fungal and Bacterial Phytopathogens of Tomato (Solanum lycopersicum L.) Plants. Horticulturae, 10(10), 1095. https://doi.org/10.3390/horticulturae10101095





